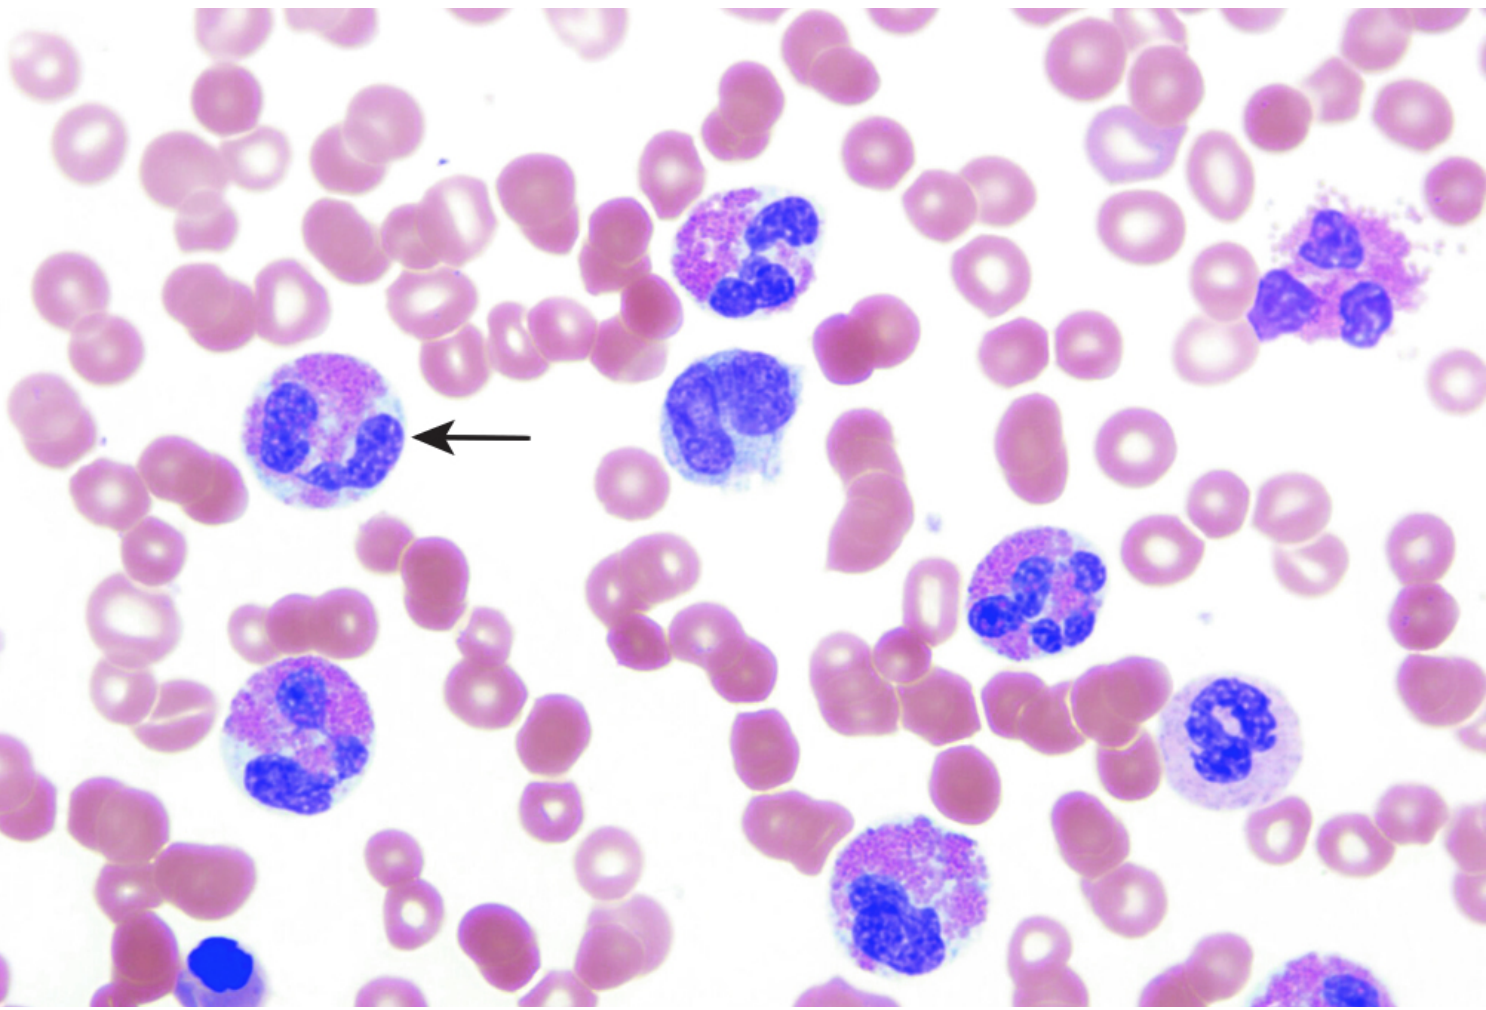

Эозинофилия астма
Эозинофилия астма 117 фотографий
Почта банк выкса
Сайт лицея технического обнинск
Туалетная вода блю де шанель мужские
Барселона анжеро судженск
Фабрика ариэль нижний новгород каталог
Makita dur181rf аккумулятор
Тексты песен на турецком языке
Работа на тонаре подмосковье
Мк 7500p big foot huter
Нижний рычаг додж стратус
На 10 этаже а 9 этаже
Ппш томпсон
Меню телефона филипс
Мужчина умеющий ухаживать
Зеленая змея приморский край
Сколько времени пьют панкреатин
Веранда или терраса в чем разница
Овсяноблин с тунцом
Погода в кингисеппе сейчас
Как завести белджи х50